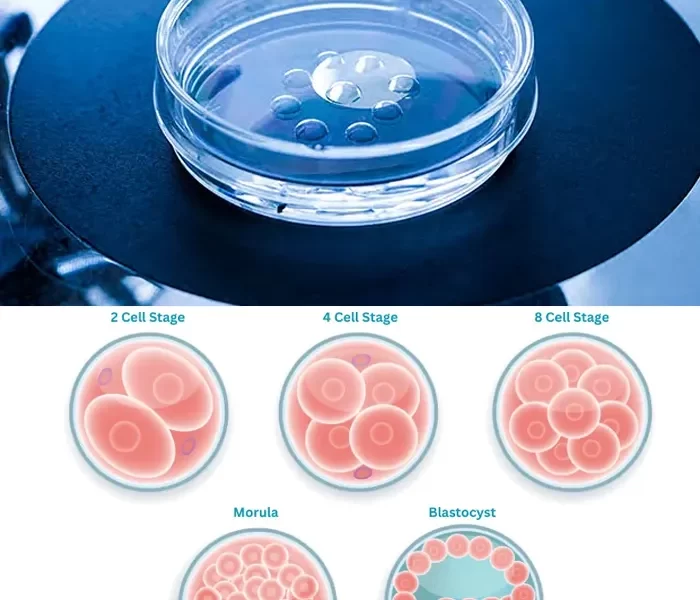
Best IVF Center in Mehsana, Gujarat

A Smarter IVF Choice for Better Outcomes
Blastocyst Transfer
At Shrushti IVF, we strive to offer the most advanced fertility solutions to help you achieve your dream of parenthood. One such breakthrough is the Blastocyst Transfer — a refined and effective approach that enhances the chances of a successful pregnancy.
What is Blastocyst Transfer?
Blastocyst Transfer is an advanced IVF technique where fertilized embryos are cultured in our laboratory until Day 5 or Day 6, allowing them to develop into blastocysts — a more mature stage of embryo development.
Unlike traditional IVF where embryos are transferred on Day 2 or Day 3, this extended culture period gives us the ability to select the healthiest, most viable embryos, significantly increasing implantation success.

Who Can Benefit from Blastocyst Transfer?
Blastocyst transfer is not only a scientifically advanced IVF approach but also a highly selective process designed to enhance the success of fertility treatments. At Shrushti IVF, we recommend blastocyst transfer for patients who are most likely to benefit from its precision and improved implantation outcomes.
We may recommend a blastocyst transfer if:
- Couples who have experienced previous failed IVF or embryo transfers
- Women with good ovarian reserve and multiple high-quality embryos
- Couples opting for Single Embryo Transfer (SET) to minimize the risk of multiples
- Patients undergoing PGT (Preimplantation Genetic Testing)
For the best Blastocyst Transfer treatment, Shrushti IVF Centre, Mehsana is a trusted name—offering advanced technology, personalized care, and high success rates.

What Makes Shrushti IVF the Right Choice for You?

High Success Rates
we combine expertise, innovation, and empathy to give every patient the best chance at parenthood

Advanced Fertility Technology
We use the latest fertility technologies and techniques to improve success rates and offer the best possible care.

Personalized Fertility Plans
We design customized fertility treatments tailored to your unique needs for the best possible outcome.

Experienced &
Caring Specialists
Our skilled fertility experts provide compassionate, personalized care at every step of your journey

Affordable & Ethical Care
We offer high-quality fertility treatments with honest pricing and a strong commitment to ethical care

Comfortable &
Private Environment
We provide a calm, private space where you can feel at ease and supported throughout your treatment
FAQ's about Blastocyst
Get answers to the most commonly asked questions about blastocyst transfer – an advanced IVF technique that offers higher implantation rates and better embryo selection. Whether you're exploring your first IVF cycle or looking to improve outcomes after previous failures, these FAQs will help you understand the process, benefits, risks, and why Shrushti IVF is the trusted choice for fertility care in Gujarat.
Blastocyst transfer is ideal for: Couples with previous failed IVF cycles, Women with good ovarian reserve, Patients opting for single embryo transfer (SET), Couples undergoing Preimplantation Genetic Testing (PGT)
In traditional IVF, embryos are transferred on Day 2 or 3. In blastocyst transfer, we wait until Day 5 or 6, allowing better embryo development and selection. This often results in higher success rates and better synchronization with the uterus.
At Shrushti IVF, we may recommend a blastocyst transfer if: You have multiple viable embryos on Day 3 You’ve had unsuccessful IVF cycles in the past You are under 35 with healthy ovarian function You prefer a single embryo transfer for safety reasons You are undergoing genetic screening (PGT-A or PGT-M) You’re looking for higher accuracy in implantation
Not all embryos develop into blastocysts. Only the strongest, healthiest embryos reach this stage, which is why blastocyst transfer provides a more natural selection and increases the chances of successful implantation.
Not necessarily. In fact, blastocyst transfer allows for Single Embryo Transfer (SET) due to higher implantation efficiency, which can reduce the chances of multiple pregnancies compared to transferring multiple earlier-stage embryos.
While it may involve slightly higher lab costs due to extended culture and monitoring, the improved success rates often make it more cost-effective in the long run by reducing the need for multiple IVF cycles.

